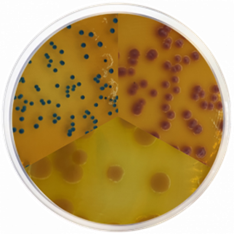

Optimising Microbiological Analysis for Enhanced Cosmetic Quality Control
Microbiological analysis plays a vital role in ensuring the quality and safety of both cosmetic products and their raw materials. However, to achieve reliable and valid results, it is essential to avoid common mistakes that could lead to erroneous findings and put consumers at risk. In this article, we will explore the most common mistake in microbiological analysis and discuss the importance of dilution in obtaining accurate results.
Common Mistakes in Microbiological Analysis
Cosmetic products come in various formats, including powders, liquids, and oils, making them diverse in nature. Additionally, these products often contain preservatives to maintain stability during storage and use. It is crucial to note that preservatives should only be added to eliminate microorganisms and prevent product contamination. However, these substances can interfere with the growth of microorganisms, making it challenging to detect contamination during microbiological control. As a result, diluting the sample before analysis becomes essential.

Neutralisation and Dilution Process
To neutralise preservatives and enable effective microbiological control, the first step is dilution. Generally, an initial dilution of 1:10 is performed using a liquid medium containing substances like lecithin, polysorbate 80, or sodium thiosulfate. This dilution and neutralisation process is crucial to obtain accurate and quantitative results. ISO standards recommend several widely used media, including Eugon LT 100 Broth, Dey-Engley Neutralising Broth, Modified Letheen Broth, and Bereens Diluent. It is worth mentioning that Eugon LT 100 Broth underwent a formulation change in recent years due to the EU ban on Triton X-100 compound.
Apart from the recommended media, alternative methods such as CondaChrome® line with specialised media for cosmetic samples are available. CondaChrome® PEC Agar, for instance, enables the simultaneous detection of E. coli, P. aeruginosa, and C. albicans. These alternative methods cater to the specific needs of the cosmetic industry, offering effective microbiological analysis options.
Beyond Neutralisation: Dilution's Significance
Performing the sample dilution and neutralisation step is not only crucial for neutralising preservatives but also for obtaining accurate and quantitative results. Applying the sample directly to a culture medium without neutralisation increases the risk of false-negative results. Additionally, dilution allows for precise measurement of the sample analysed, which is essential for reference methods that start with a known amount of sample, such as 1 g/ml of the product.
Microorganism Detection: Alarming Insights
Even the presence of a small number of microorganisms in a tested cosmetic product can potentially lead to severe issues. Therefore, it is crucial to identify and assess any observed colonies, regardless of whether they exceed the established limits. Identifying the type of microorganism helps determine possible sources of contamination, perform risk assessments, and derive conclusions to improve quality control measures.
Eco Cosmetics: Navigating Green Risks
The growing popularity of organic and natural ingredients in cosmetics, driven by environmental awareness and concerns over the use of chemicals, presents a new risk situation. While organic and natural ingredients do not guarantee safety, consumers may mistakenly believe so, particularly when compared to traditional cosmetics that use chemical preservatives. Hence, it is vital to follow the standard analytical methods for the analysis of organic and natural cosmetics, as these ingredients may contain a higher microbial load and put consumers at risk if not properly preserved.

At Lab Unlimited, we understand the significance of microbiological analysis for enhanced cosmetic quality control. As a trusted supplier of Condalab products, we offer a wide range of reliable and high-quality microbiological analysis solutions. Visit our website to explore our extensive product range and find the perfect solution for your laboratory needs.
|
To find out more: |
